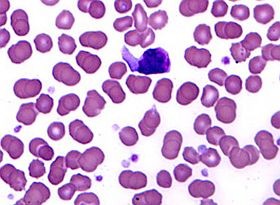
Betegségek kapcsolata: mi mindenre kellene gondolni...

A mononukleózis és a napfényhiány növeli a szklerózis multiplex kockázatát. Kapcsolat lehet a mononukleózis, a kevés napfény és a szklerózis multiplex kockázata között – olvasható a Neurology április 19-i számában.
Dr. George C. Ebers és az Oxfordi Egyetem munkatársai olyan környezeti tényezők hatását vizsgálták, mint a tizenévesek között terjedő vírusfertőzés, a mononukleózis, valamint az alacsony szintű napfénybehatás. Mindkét tényező általánosnak számít Nagy-Britanniában, és mindkét faktor igen gyakran található meg szklerózis multiplexes betegek kórtörténetében.
Betegségek kapcsolata: mi mindenre kellene gondolni...
Forrás: Medipress
A kutatók munkájuk során az angol egészségügyi szolgáltatások alapján vezetett adatbázist tanulmányozták, 56 681 szklerózis multiplexes, és 14 621 mononuleózisos esetre koncentráltak. Az elemzésbe bevonták a NASA adatbázisában szereplő, brit UV-terhelésre vonatkozó adatokat. Megállapították, hogy a napfény és a mononukleózis vírus az esetek mintegy háromnegyedében érhető tetten, az összes eset 61 százalékért a kevés napfény egyedül tehető felelőssé.
Ebers doktor magyarázata szerint a kevés napfény csökkent D-vitaminszinthez vezethet, ami megváltoztatja a mononukleózisért felelős Epstein-Barr-vírusra adott immunológiai választ. A további vizsgálatok célkeresztjében az emelkedett UV-B-terhelés, a kívülről bevitt D-vitamin, illetve az Epstein-Barr-vírus elleni védőoltás állhat.
Kövesse az Egészségkalauz cikkeit a Google Hírek-ben, a Facebook-on, az Instagramon vagy a X-en,Tiktok-on is!








